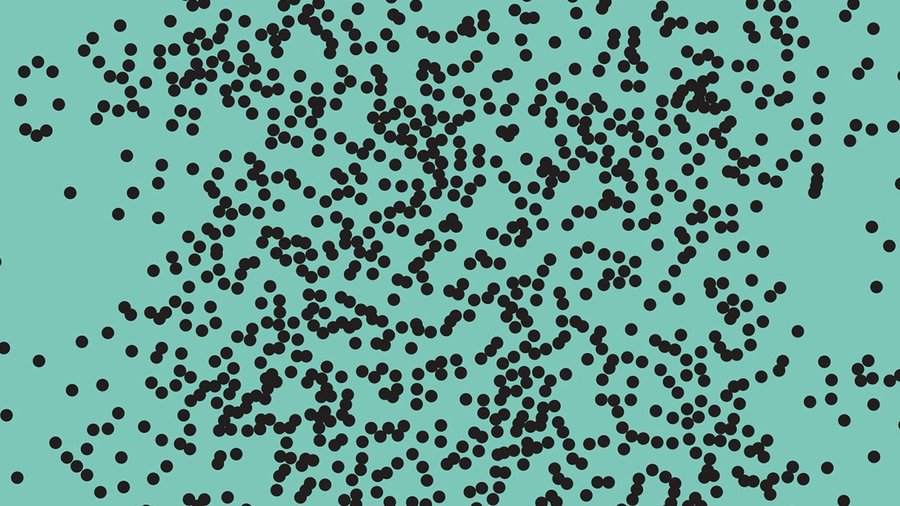

Siri Helle to Granta
Granta Books has secured World English rights to Siri Helle’s book The Hand Made Tale after an auction.

Granta Books has secured World English rights to Siri Helle’s book The Hand Made Tale after an auction.

Nazneen Khan-Østrem’s higly praised book about immigrant London has been acquired in an auction by Little, Brown’s Robinson imprint.

The renowed MIT Press has just bought World English rights to Erik Martiniussen’s The War against Bacteria.

Therese Tungen is on the shortlist for the European Union Prize for Literature 2020 for her book Love, or something like it.
Erik Martiniussen has just published his new book The War against Bacteria to critical acclaim from a collective Norwegian Press. With two newspapers giving it the highest score possible, 6 out of 6, and the third calling it one of the best books of the year (already) – this surely is a fantastic launch.

Even though London Book Fair was cancelled, our new catalogue is fresh out of the printer.

2020 is off to a good start, lots of books are moving on out into the world. Here’s a roundup off the latest deals.

The UK rights to John Kåre Raake’s thriller The Ice has been acquired by the renowned British publisher Pushkin Press. – The Ice is a brilliantly paced and plotted thriller — taut, claustrophobic, and all played out in the freezing darkness of the North Pole. I can’t wait for Pushkin Vertigo to publish it in English, says the editor Daniel Seton.

Anders Røyneberg’s book GREEN JOY is set to travel out into the world. The estemeed publishing house Quadrille has bought World English rights and will publish it in the UK. In Australia it will be published by Hardie Grant.

The first book about Ingrid Winter written by Janne Stigen Drangsholt is going to become a movie.
The Marvelous Misadventures of Ingrid Winter will be produced by the Norwegian production company Chezville.

Frankfurt Book Fair 2019 was special this year with Norway as the Guest of Honour.
This meant a program with a lot of of authors from Northern Stories participating

Congratulations to Jens M. Johansson for being nominated to the prestigious NRK P2 listener prize for best Norwegian novel of 2019!

Lots of books has been sold this fall. Here’s an update.

Linka Neumann’s highly successful first book Wilderness Sweaters is sold to be published both in Sweden and Finland.

A huge congratulation to Nilas Johnsen who has been nominated to the prestigous Brage prize for the best Norwegain non-fiction book of 2019. His book Erdogan. The making of Turkey’s strongman is one of four nominees to the prize which will be awarded on November 21.

We are proud to welcome Camara Lundestad Joof to Northern Stories – and excited to travel to Frankfurt on Monday to present her her important book I talk about it all the time.